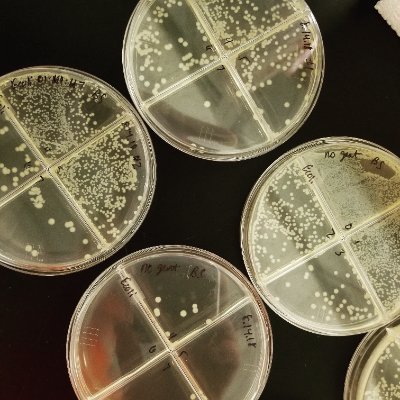
robinsonlab_WVU's profile picture. Robinson Lab @WVUHealth, specializing in host-pathogen interactions of the #neonatal immune system: bacterial #sepsis, #tuberculosis, #IL27, #vaccines

LegleiterLab
@LabLegleiter
A biophysical chemistry research group investigating neurodegenerative diseases at the University of Nevada
You might like
"The establishment and growth of scientific communities require long-term planning, political backing, and social and economic support. In many Latin American countries, these entities have been repeatedly shaken …," writes Antonio Lazcano in a new #ScienceEditorial.…

Congratulations to Dr. Elizabeth Yates (former Legleiter Lab member) on receiving the outstanding researcher from a primary undergraduate institution award at the Biophysical Society Meeting in Los Angeles.

"[My adviser] told me that instead of focusing on finding a dream job, I should think about what I am good at and what makes me happy at least 80% of the time. This advice surprised me at first, but it ended up being exactly what I needed to hear." scim.ag/7aJ
Many don’t realize that the first people Hitler sent to his concentration camps weren’t everyday Jewish citizens, but his political opponents. So, when Trump rants about retribution, locking up his opponents, and giving them “very long sentences,” I can’t help but take him…
unr.edu/nevada-today/n… I am truly excited about this new professional opportunity and very impressed by my new colleagues at UNR.
biophysics.org/news-room/eliz… Congratulations to lab alum, Elizabeth Yates, on this well deserved recognition from the BPS.
biophysics.org
Elizabeth A. Yates to Receive 2025 PUI Faculty Award
ROCKVILLE, MD – The Biophysical Society is pleased to announce that Elizabeth A. Yates, PhD, of the United States Naval Academy, has been named the recipient of the 2025 PUI Faculty Award....
I’m one of those that left because of the broken trust. insidehighered.com/news/faculty-i…
I’m excited to announce that the Legleiter Lab is moving to the Department of Biochemistry and Molecular Biology at the University of Nevada in Reno.
Reminder! Student-Run Seminar Today at 3:30! Link below.
Chemistry Student-Run Seminar Series - Claudia Vega on "Science for the People: Strategies for Saving the Amazon" THIS Wednesday, September 27th, 2023, 3:30pm EST, Link: bitly.ws/VyRd

Meet our undergraduate chemistry majors! Introducing Nate Kazienko, a Senior participating in research with @Hilton_Lab and planning to attend dental school!

Huntingtin Protein Purification and Experimentation: An Innovative Undergraduate Research-Based Biochemistry Experiment pubs.acs.org/doi/10.1021/ac…
Today’s the day to help the LSU community. Get your vaccine: lsu.edu/roadmap/vaccin…
With the upcoming return to campus, I found this an interesting read. How faculty can support college students’ mental health this fall (opinion) insidehighered.com/views/2021/07/…
Our lab’s new paper on the impact of crowding on huntingtin aggregation at interfaces has just been published. authors.elsevier.com/a/1dNMI3IyxDzo…
Congtats to Adewale Adegbuyiro for successfully defending his dissertation. Coincidentally, his paper in press posted on BBA-Biomembranes while he was defending. sciencedirect.com/science/articl…
Congrats to these two for all they accomplished in grad school.

United States Trends
- 1. Eagles 127K posts
- 2. Eagles 127K posts
- 3. Ben Johnson 21.1K posts
- 4. Jalen 27.7K posts
- 5. Caleb 47.6K posts
- 6. Philly 27.1K posts
- 7. Patullo 13K posts
- 8. #BearDown 2,445 posts
- 9. AJ Brown 6,068 posts
- 10. Sirianni 8,094 posts
- 11. Lane 55.8K posts
- 12. Black Friday 520K posts
- 13. Howie 2,805 posts
- 14. #GoDawgs 5,654 posts
- 15. Georgia Tech 5,269 posts
- 16. Utah State 2,017 posts
- 17. GOOD BETTER BEST 6,277 posts
- 18. NFC East 2,049 posts
- 19. Swift 55.6K posts
- 20. Lurie 2,040 posts
Something went wrong.
Something went wrong.